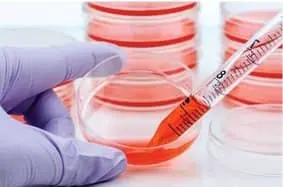

20+ ans d’expertise en biologie moléculaire
1 000+ panels de voies de signalisation validés
Cités dans plus de 100 publications scientifiques
Les signalisation cellulaire qPCR arrays d’AnyGenes® offrent plus de 1 000 tests validés expérimentalement et des réactifs haute performance, garantissant des résultats fiables et reproductibles, même avec de faibles quantités d’ARN ou des échantillons complexes.
Nos solutions permettent aux chercheurs de découvrir rapidement des voies moléculaires clés, des mécanismes immunitaires et des biomarqueurs pertinents, accélérant les avancées en biologie moléculaire.
Partenaire de confiance depuis plus de 17 ans

Demarrez vos recherches sur la signalisation cellulaire dès aujourd’hui et obtenez des résultats fiables rapidement ou Demandez une consultation gratuite.
Avec les signalisation cellulaire qPCR arrays AnyGenes®, vous bénéficiez non seulement de tests de haute qualité, mais aussi d’un logiciel gratuit d’analyse de données inclus avec chaque kit. Cela vous permet de :
Grâce aux signalisation cellulaire qPCR arrays AnyGenes®, les chercheurs ont identifié des changements transcriptomiques à l’échelle du génome dans le syndrome de Cornelia de Lange. Nos arrays ont permis un profilage précis de l’expression génique, même avec des échantillons rares ou de faible quantité.
Les SignArrays® ont facilité l’analyse détaillée des voies de signalisation endothéliale dans des études sur l’hypertension pulmonaire, apportant des insights clés pour la recherche translationnelle et le développement thérapeutique.
Les qPCR assays lncRNA validés ont permis une quantification efficace des lncRNAs chez des patients infarctus du myocarde, soutenant la découverte rapide de biomarqueurs pertinents.

Personnalisez vos propres voies de signalisation (SignArrays®) avec les biomarqueurs de votre choix !
Téléchargez simplement notre fiche d’information personnalisée SignArrays®, complétez-la, puis envoyez-la à [email protected] pour démarrer votre projet.
La satisfaction de nos clients est notre priorité, découvrez leurs avis ci-dessous :
“ I am highly satisfied with the exceptional services provided by AnyGenes®. Their bespoke products and insightful advices have significantly contributed to my research endeavors. The team at AnyGenes is consistently professional, approachable, and highly responsive, always available to address any needs promptly.
The customized SignArrays developed by AnyGenes were pivotal in conducting critical analyses that were published in high-impact journals (doi: 10.1161/CIRCULATIONAHA.114.008750 and doi: 10.1165/rcmb.2019-0015OC).
These signaling pathways meticulously crafted to meet my specific requirements, enabled comprehensive studies on the modulation of endothelial-mesenchymal transition, BMP signaling pathways, and integrated stress response. ”

“ I deeply appreciate the outstanding support provided by AnyGenes®. Their expertise and thoughtful guidance have been instrumental in advancing my research. The team at AnyGenes maintains a high level of professionalism, remains easily accessible, and responds promptly to any inquiries, ensuring a seamless experience.
The customized SignArrays developed by AnyGenes played a crucial role in analyzing 2D and 3D neural cells derived from patients with neurodevelopmental disorders, as well as in the development of a trilineage Q-PCR array. Precisely designed, these arrays provided valuable insights into NPC stress responses and pathomechanisms. Additionally, the trilineage array served as a crucial quality control tool for iPSC characterization. ”


